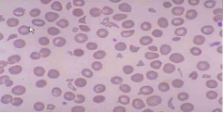

房間隔缺損封堵術(shù)后并發(fā)機械性溶血1例
病歷資料 患者,男性,50歲,因“反復上腹部疼痛4月余,再發(fā)加重伴醬油色尿1周”入院。查體:血壓 113/70mmHg,心率 50次/分,精神差,少言懶語。全身皮膚及鞏膜輕度黃染,雙肺呼吸音粗,未聞及干濕性啰音。心尖搏動在左第六肋間鎖骨中線外1cm,心界向左下擴大,各瓣膜聽診區(qū)未聞及病理性雜音。腹部平坦,劍突下及右上腹部壓痛明顯,Murphy征陽性。雙下肢無水腫。初步診斷:1.溶血性黃疸?2.先天性心臟病,房間隔缺損封堵術(shù)后,心臟擴大,心功能III級;1月前在當?shù)蒯t(yī)院行心彩(圖1)檢查:先天性心臟病,房間隔缺損(ASD),缺損直徑為21 mm,房水平左向右分流;估測肺動脈收縮壓72mmHg,在局麻下行“經(jīng)皮穿刺ASD 封堵術(shù)”,選擇直徑32mm,(先建科技公司)雙盤ASD封堵器采取左上肺靜脈釋放法,一次封堵成功。封堵后即可測肺動脈收縮壓為65mmHg。術(shù)后復查超聲未發(fā)現(xiàn)殘余分流。術(shù)后1月患者突然出現(xiàn)乏力、納差、醬油色尿。尿常規(guī): 尿膽原(-),隱血+++,尿蛋白+++,膽紅素+,白細胞+, 提示血紅蛋白尿;血常規(guī):WBC 11.13*10^9/L,RBC 3.47*10^12/L,HBG 79g/L,PLT 232*10^9/L;肝功能:TBI 3.4umol/L,DBI 5.9umol/L,IBI 57.5umol/L,GPT 83U/L,AST 165U/L。心電圖:竇性心律,完全性右束支傳導阻滯。入我院后復查心彩(圖2):1.房間隔缺損封堵術(shù)后,封堵器周圍未見異常血流信號;2.右心擴大,肺動脈內(nèi)徑增寬,輕度肺動脈高壓;肺動脈瓣、三尖瓣少量反流。完善溶血全套、CD55、CD59、骨髓細胞學檢查,Coombs試驗陰性, 除外自身免疫性溶血,Ham試驗陰性,陣發(fā)性睡眠性血紅蛋白尿可能性小。Rous試驗陽性,提示血管內(nèi)溶血。雖然復查心彩封堵器周圍未見異常血流信號,但仍不能排外因封堵器原因造成機械性溶。立即給予停用拜阿司匹林、大劑量糖皮質(zhì)激素(甲潑尼龍80mg/天)、輸入洗滌紅細胞、抗感染治療、碳酸氫鈉堿化尿液等對癥支持治療。治療20天后患者腹痛、乏力、納差明顯好轉(zhuǎn),小便顏色逐漸轉(zhuǎn)清,HBG 113g/g;尿常規(guī)、血生化正常,好轉(zhuǎn)出院。


討論
房間隔缺損封堵術(shù)(ASD)是近幾年發(fā)展起來的先天性心臟病房間隔缺損的有效治療方法之一。但存在并發(fā)癥發(fā)生可能:殘余分流、機械性溶血、異位栓塞、血管并發(fā)癥及感染、心房穿孔、心包壓塞、主動脈穿孔等。心臟醫(yī)源性機械性溶血多見于心臟瓣膜病換瓣術(shù)后,與殘余分流產(chǎn)生高速血流及高速剪切力(>3000dynes/m2)導致紅細胞破壞有關(guān)。
隨著先天性心臟病介入治療技術(shù)突飛猛進的發(fā)展,介入手術(shù)越來越常見,術(shù)后發(fā)生溶血并發(fā)癥病例諸有報道,但多見于動脈導管未閉合室間隔缺損封堵術(shù)后存在殘余分流。房間隔缺損因為雙心房之間壓力差較小,不會發(fā)生高速血流和高剪切力,即使存在小量殘余分流血液也不應出現(xiàn)紅細胞破壞情況。


1961年有報道外科手術(shù)修補原發(fā)性ASD后出現(xiàn)溶血并發(fā)癥,后經(jīng)二次開胸發(fā)現(xiàn)修補部位存在殘余分流,考慮二尖瓣反流穿過房間隔,紅細胞通過修補器被破壞所致,經(jīng)過再次修補后溶血消失。

國內(nèi)報道過1例VSD介入封堵殘余漏患者,術(shù)中主動脈瓣上造影課件主動脈瓣右冠狀動脈瓣穿孔,仍堅持封堵,術(shù)后復查UCG未見封堵器周圍異常血流出現(xiàn)。術(shù)后第一天即出現(xiàn)溶血,引起溶血原因可能為高速血流穿過主動脈右冠狀動脈瓣,直接沖擊在封堵器的表面,引起紅細胞破裂。本例患者的溶血原因考慮為房間隔缺損較大,殘端短小且軟,且患者存在肺動脈高壓,為該手術(shù)相對禁忌癥,但考慮介入手術(shù)風險較小且患者及家屬強烈要求封堵術(shù),故給予ASD封堵治療,術(shù)后發(fā)生機械性溶血?;颊咝牟史舛缕髦車撮g殘余分流,考慮紅細胞在較大的網(wǎng)狀雙盤結(jié)構(gòu)中流動所致,經(jīng)停用拜阿司匹林加快網(wǎng)狀雙盤封堵器表面血栓形成、大劑量糖皮質(zhì)激素抑制紅細胞破壞、穩(wěn)定細胞膜、輸入洗滌紅細胞等保守治療后,患者乏力、納差等癥狀明顯好轉(zhuǎn),尿色逐漸由醬油色變?yōu)闇\黃色,尿常規(guī)正常。通過本病例,可見對于較大房間隔缺損患者,掌握封堵器大小亦是介入術(shù)成功與否的關(guān)鍵。
(文章部分圖文來源于網(wǎng)絡,版權(quán)歸原作者所有,如有侵權(quán),請聯(lián)系醫(yī)院刪除)
微信掃碼預約

吉公網(wǎng)安備 22038102000293號 吉ICP備18000181號